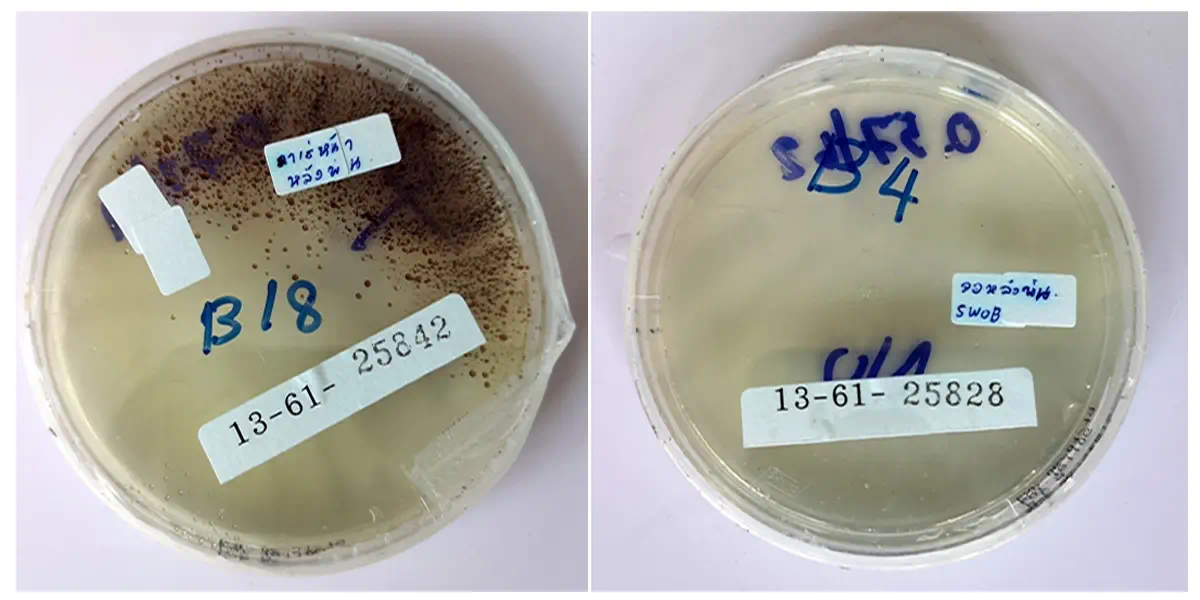

น้ำยาฆ่าเชื้อโรคได้ทุกชนิด เช่น ไวรัสแบคทีเรีย Mers Sars-cov-2 HIV ไข้หวัดใหญ่ influenza virus สามารถย่อยสลายได้เองตามธรรมชาติไม่กัดกร่อนวัสดุ หัวเชื้อ เจือจาง ได้ 200 เท่า ป้องกันยาวนานถึง 14 วัน และ เป็น น้ำยาฆ่าเชื้อ ที่ใช้ได้ทุกหน้างานหลั่งหลายสถานที่เช่น โรงพยาบาล โรงแรม ออฟฟิศ สนามบินห้องประชุม ศูนย์ดูแลผู้ป่วย ผู้สูงอายุ โรงเรียนเด็ก ได้รับการรับรองจาก องค์กร สถาบันทั้งในและต่างประเทศ ฆ่าเชื้อได้ตาย 99% น้ำยามีประสิทธิภาพที่ดี จาก มหิดล อย กรมวิทยาศาสตร์การแพทย์ และ ประเทศอังกฤษ
หมวดหมู่ : น้ำยาฆ่าเชื้อ , 
แบรนด์ : CHEMGENE

CHEMGENE HLD4H คือ น้ำยาฆ่าเชื้อ ระดับการแพทย์ (High Level Medical Grade) ที่ได้รับความไว้วางใจจากห้องปฏิบัติการในอังกฤษและหน่วยงานด้านสาธารณสุข เช่น NHS England ด้วยประสิทธิภาพการกำจัดเชื้อไวรัส เชื้อแบคทีเรีย และเชื้อราหลายสายพันธุ์ภายใน 1 นาที และสามารถปกป้องพื้นผิวได้ยาวนาน ถึง 14 วัน
ผลิตภัณฑ์นี้ถูกออกแบบมาเพื่อรองรับการใช้งานจริงในหลากหลายสถานการณ์ ไม่ว่าจะเป็นในโรงพยาบาล คลินิก ห้องแล็บ หรือพื้นที่ที่ต้องการมาตรฐานความสะอาดสูง จึงถูกยกให้เป็นหนึ่งใน น้ำยาฆ่าเชื้อโรงพยาบาล ที่เชื่อถือได้และได้รับการยอมรับในระดับสากล
นอกจากนี้ CHEMGENE HLD4H ยังสามารถใช้เป็น น้ำยาทำความสะอาดฆ่าเชื้อ สำหรับพื้นผิวทั่วไป ไม่ว่าจะเป็นโต๊ะ เก้าอี้ ลูกบิดประตู หรืออุปกรณ์ที่มีการสัมผัสบ่อย ช่วยลดการแพร่กระจายของเชื้อโรคได้อย่างมีประสิทธิภาพ โดยไม่ก่อให้เกิดความเสียหายต่อพื้นผิวและปลอดภัยต่อผู้ใช้งาน

เด็กเล็กเสี่ยงติดเชื้อ RSV ได้ง่าย และหากอาการรุนแรงอาจเป็นอันตรายถึงชีวิต ค่าใช้จ่ายในการรักษาอาจสูงถึงหลักหมื่นบาท ขณะที่วัคซีนป้องกันก็มีราคาสูง ไม่ใช่ทุกครอบครัวจะเข้าถึงได้
สิ่งสำคัญคือ การป้องกันตั้งแต่ที่บ้าน ดูแลบ้านให้ปลอดเชื้อด้วย CHEMGENE HLD4L และ CHEMGENE HLD4H
ฆ่าเชื้อไวรัสและแบคทีเรียได้จริง รวมถึงเชื้อ RSV
ปลอดภัยต่อเด็กเล็ก ผู้ใหญ่ และสัตว์เลี้ยง
ใช้งานง่าย เหมาะกับบ้าน โรงเรียนอนุบาล ศูนย์เด็กเล็ก และสถานพยาบาล
ปกป้องลูกน้อยจาก RSV และเชื้อโรคร้ายแรง เริ่มต้นที่บ้านของคุณด้วย CHEMGENE

ด้วย น้ำยาฆ่าเชื้อ Chemgene HLD4L


CHEMGENE HLD4H
ตัวช่วยปกป้องบ้านและคนที่คุณรัก จากเชื้อโรคที่มองไม่เห็น
ไวรัสโคโรนาสายพันธุ์ใหม่ยังคงระบาดอย่างต่อเนื่องในปี 2025 โดยล่าสุดยอดผู้ติดเชื้อสะสมในประเทศไทยพุ่งขึ้นขณะที่ยอดผู้เสียชีวิตอยู่ที่ 112 ราย ส่งผลให้ภาครัฐกลับมาเข้มงวดในมาตรการป้องกันและเฝ้าระวัง พร้อมเน้นย้ำการฉีดวัคซีนและการสวมหน้ากากในพื้นที่เสี่ยง
อันตรายจาก COVID-19: ไม่ใช่แค่หวัดธรรมดา
ไวรัสโควิด-19 ยังคงเป็นภัยเงียบที่คร่าชีวิตผู้คนทั่วโลก แม้จะผ่านมาหลายปีแล้ว แต่เชื้อกลายพันธุ์ใหม่ยังคงแพร่ระบาดได้ง่าย และรุนแรงในบางราย โดยเฉพาะผู้สูงอายุ ผู้มีโรคประจำตัว และผู้ที่ไม่ได้รับวัคซีนกระตุ้น

CHEMGENE HLD4H คือ น้ำยาฆ่าเชื้อระดับการแพทย์ ที่ได้รับความไว้วางใจจากหลากหลายหน่วยงาน รวมถึง คุณชัชชาติ สิทธิพันธุ์ ผู้ว่าราชการกรุงเทพมหานคร ซึ่งเลือกใช้ในการพ่นฆ่าเชื้อเพื่อควบคุมและป้องกันการแพร่ระบาดของไวรัสโควิด-19 ในสถานที่สำคัญของกรุงเทพฯ
สำหรับผู้ที่กำลังสงสัยว่า น้ำยาฆ่าเชื้อ ยี่ห้อไหนดี ที่สามารถมั่นใจได้ในด้านคุณภาพและความปลอดภัย CHEMGENE HLD4H ถือเป็นคำตอบที่เหมาะสมที่สุด ด้วยการรับรองจากสถาบันชั้นนำและประสิทธิภาพที่พิสูจน์แล้วว่าสามารถใช้เป็น น้ำยาฆ่าเชื้อโควิด19 ได้จริง
นอกจากนี้ยังเป็น น้ำยาฆ่าเชื้อ High Level ที่ใช้งานได้หลากหลาย ทั้งในโรงพยาบาล ห้องแล็บ สถานศึกษา หรือแม้แต่ภายในบ้าน รวมถึงยังปลอดภัยพอที่จะใช้เป็น น้ำยาฆ่าเชื้อสำหรับสัตว์เลี้ยง ช่วยลดความเสี่ยงจากเชื้อโรคที่อาจสะสมตามพื้นหรืออุปกรณ์สัตว์ได้อย่างมีประสิทธิภาพ
ด้วยคุณสมบัติที่สามารถใช้เป็นทั้ง น้ำยาฆ่าไวรัส และ น้ำยา ฆ่า เชื้อ แบคทีเรีย CHEMGENE HLD4H จึงเป็นผลิตภัณฑ์ที่ครอบคลุมและคุ้มค่า ตอบโจทย์ทุกความต้องการด้านสุขอนามัยและการป้องกันโรคในทุกสถานการณ์
Before & After
ทดสอบการฆ่าเชื้อจริงจากหน้างานได้ผลเชื้อตาย 99.99%

ผลิตภัณฑ์นี้ได้รับการทดสอบจาก มหาวิทยาลัยมหิดล และสถาบันสาธารณสุขชั้นนำทั้งในและต่างประเทศ
โดยสามารถฆ่าเชื้อไวรัสได้ภายใน 1 นาที และปกป้องพื้นผิวได้นานถึง 14 วัน พร้อมทั้งปลอดภัยต่อคน สัตว์เลี้ยง และสิ่งแวดล้อม จึงได้รับความนิยมใช้อย่างแพร่หลายทั้งในโรงพยาบาล หน่วยงานราชการ และภาคเอกชน
สำหรับผู้ที่สนใจรายละเอียด CHEMGENE HLD4H ราคา ถือว่าคุ้มค่าเมื่อเทียบกับคุณภาพระดับสากล เพราะจัดอยู่ในกลุ่ม น้ำ ยา High Level Disinfection ที่มีประสิทธิภาพสูงกว่าน้ำยาฆ่าเชื้อทั่วไป เหมาะสำหรับสถานที่ที่ต้องการมาตรฐานด้านสุขอนามัยขั้นสูงสุด
ด้วยคุณสมบัติที่เป็น น้ำยาฆ่าเชื้อ High Level ทำให้สามารถกำจัดเชื้อไวรัสและแบคทีเรียได้อย่างมีประสิทธิภาพ อีกทั้งยังปลอดภัยพอที่จะใช้เป็น น้ำยาฆ่าเชื้อสำหรับสัตว์เลี้ยง ช่วยลดความเสี่ยงจากเชื้อโรคที่อาจสะสมบนพื้นและอุปกรณ์ได้อย่างมั่นใจ
นอกจากนี้ยังถูกยกให้เป็น น้ำยาฆ่าไวรัส และ น้ำยา ฆ่า เชื้อ แบคทีเรีย ที่ใช้ได้ทั้งในระดับครัวเรือนและระดับองค์กร อีกทั้งยังทำหน้าที่เป็น น้ำยาทำความสะอาดฆ่าเชื้อ ที่เหมาะสำหรับทุกพื้นผิว ไม่ว่าจะเป็นโต๊ะทำงาน ลูกบิดประตู หรือพื้นห้องน้ำ
สำหรับพื้นที่ที่มีปัญหาเรื่องเชื้อรา CHEMGENE HLD4H ยังสามารถใช้เป็น ยา พ่นฆ่าเชื้อรา ได้อย่างมีประสิทธิภาพ ช่วยป้องกันการเกิดเชื้อราซ้ำ และรักษาความสะอาดของพื้นผิวให้ปลอดภัยต่อการใช้งานในระยะยาว

มั่นใจในคุณภาพและมาตรฐานระดับโลก! CHEMGENE HLD4H น้ำยาฆ่าเชื้ออเนกประสงค์จากอังกฤษ ผ่านการทดสอบและรับรองจากหน่วยงานชั้นนำ ฆ่าเชื้อไวรัส แบคทีเรีย และเชื้อราต่างๆ รวมถึง Covid-19, RSV, ไข้หวัดใหญ่ และ Norovirus ได้อย่างรวดเร็วภายใน 1 นาที ด้วยประสิทธิภาพสูงถึง 99.85% ปลอดภัยต่อคนและสัตว์เลี้ยง ไม่กัดกร่อน ย่อยสลายได้ และปกป้องยาวนานถึง 14 วัน
ด้วยคุณสมบัติขั้นสูง CHEMGENE HLD4H จึงถูกเลือกใช้เป็นทั้ง น้ำยาแช่เครื่องมือแพทย์ ที่ต้องการความสะอาดปราศจากเชื้อโรค รวมถึงการใช้งานในรูปแบบ น้ำยาพ่นฆ่าเชื้อ สำหรับห้องเรียน โรงพยาบาล อาคารสำนักงาน และสถานที่สาธารณะ
นอกจากนี้ยังเหมาะสำหรับการ ฆ่าเชื้อโรงพยาบาล ที่ต้องการมาตรฐานสูงสุดด้านสุขอนามัย และสามารถใช้เป็น น้ำยาฆ่าเชื้อโรค สำหรับครัวเรือนหรือภาคธุรกิจที่ต้องการความมั่นใจในความสะอาดและความปลอดภัยอย่างต่อเนื่อง
สำหรับงานพ่นพื้นที่ขนาดใหญ่ CHEMGENE HLD4H ยังสามารถประยุกต์ใช้เป็น น้ำยาฆ่าเชื้ออัดพ่น ร่วมกับเครื่องพ่น ULV เพื่อครอบคลุมพื้นที่ได้กว้างและทั่วถึง เหมาะสำหรับภารกิจด้านสาธารณสุขและการควบคุมโรคในชุมชน

หนึ่งในจุดเด่นที่แสดงให้เห็นถึงความน่าเชื่อถือของ CHEMGENE HLD4H คือการถูกนำไปใช้ในการ พ่นฆ่าเชื้อ ที่ “ศูนย์บริหารสถานการณ์โควิด-19 (ศบค.)” ซึ่งเป็นหน่วยงานสำคัญของประเทศไทยในการควบคุมการแพร่ระบาดของโรคโควิด-19 การได้รับเลือกใช้งานในพื้นที่ระดับนี้ สะท้อนถึงความปลอดภัย ประสิทธิภาพ และความไว้วางใจในระดับสูง
นอกจากนี้ CHEMGENE HLD4H ยังเป็นหนึ่งใน น้ำยาฆ่าเชื้อโรค ที่ได้รับการยอมรับในระดับสากล สามารถใช้ได้ทั้งในโรงพยาบาล หน่วยงานราชการ และสถานที่ที่ต้องการมาตรฐานสุขอนามัยสูงสุด อีกทั้งยังเหมาะสำหรับใช้ในครัวเรือนที่ต้องการป้องกันเชื้อโรคอย่างต่อเนื่อง
ด้วยคุณสมบัติการเป็น ยาพ่นฆ่าเชื้อรา ทำให้ CHEMGENE HLD4H ช่วยจัดการปัญหาการสะสมของเชื้อราบนพื้นผิวที่มีความชื้นสูงได้อย่างมีประสิทธิภาพ พร้อมทั้งช่วยลดความเสี่ยงในการแพร่กระจายของเชื้อโรคที่อาจก่อให้เกิดอันตรายต่อสุขภาพ
และเพราะสามารถใช้งานได้หลากหลาย CHEMGENE HLD4H จึงถูกจัดเป็นทั้งน้ำยาฆ่าเชื้อและ น้ำยาทำความสะอาดฆ่าเชื้อ ในขวดเดียวกัน ครอบคลุมทั้งการกำจัดเชื้อโรคและการดูแลพื้นผิวให้สะอาดปลอดภัย ใช้งานง่าย และเป็นมิตรต่อผู้ใช้

CHEMGENE HLD4H น้ำยาฆ่าเชื้อคุณภาพสูงจากประเทศอังกฤษ ที่ได้รับการรับรองจากหน่วยงานชั้นนำระดับโลก เช่น NHS England (สหราชอาณาจักร) และ มหาวิทยาลัยมหิดล ได้ถูกนำมาใช้ในภารกิจฆ่าเชื้อสนามบิน เพื่อเสริมความปลอดภัยให้กับผู้โดยสารและเจ้าหน้าที่ในพื้นที่ที่มีการใช้งานร่วมกันจำนวนมาก
ด้วยมาตรฐานที่เข้มงวด CHEMGENE จึงได้รับการยอมรับว่าเป็นหนึ่งใน น้ำยาฆ่าเชื้อ ที่มีประสิทธิภาพสูง สามารถกำจัดเชื้อไวรัส แบคทีเรีย และเชื้อราหลากหลายสายพันธุ์ได้ภายในเวลาอันรวดเร็ว โดยไม่ทำลายพื้นผิวหรือก่อให้เกิดอันตรายต่อผู้ใช้งาน
นอกจากนี้ยังจัดอยู่ในกลุ่ม medical disinfectant ที่เหมาะสำหรับใช้ในโรงพยาบาล ห้องแล็บ หน่วยงานราชการ และพื้นที่สาธารณะที่ต้องการความสะอาดปลอดภัยในระดับสูงสุด ทำให้ CHEMGENE HLD4H ไม่เพียงเป็นน้ำยาฆ่าเชื้อทั่วไป แต่ยังเป็นโซลูชันที่หน่วยงานระดับประเทศและระดับโลกเลือกใช้เพื่อสร้างความมั่นใจด้านสุขอนามัย


ในยุคที่เชื้อไวรัสอย่างโควิด-19 ยังคงเป็นภัยเงียบที่ต้องระวัง การเลือก น้ำยาฆ่าเชื้อ ที่มีประสิทธิภาพจึงไม่ใช่เรื่องเล็ก เพราะไม่ใช่น้ำยาทุกตัวจะสามารถฆ่าเชื้อโควิดได้จริง วันนี้เราจะพาเปรียบเทียบความแตกต่างระหว่าง CHEMGENE HLD4H น้ำยาฆ่าเชื้อเกรดการแพทย์จากอังกฤษ กับน้ำยาฆ่าเชื้อทั่วไป เพื่อให้คุณตัดสินใจได้อย่างมั่นใจ
นอกจากความสามารถในการกำจัดเชื้อไวรัสโควิด-19 แล้ว CHEMGENE HLD4H ยังถูกใช้เป็น น้ำยาฆ่าเชื้อโรคมือเท้าปาก ซึ่งเป็นโรคที่พบบ่อยในเด็กเล็กและแพร่กระจายได้อย่างรวดเร็วในโรงเรียนและสถานรับเลี้ยงเด็ก ด้วยประสิทธิภาพการกำจัดเชื้อไวรัสและแบคทีเรียที่เกี่ยวข้องกับโรคนี้ จึงช่วยลดความเสี่ยงและเพิ่มความปลอดภัยให้กับเด็กและผู้ดูแลได้มากยิ่งขึ้น
ด้วยคุณสมบัติการเป็นน้ำยาฆ่าเชื้อเกรดการแพทย์ CHEMGENE HLD4H จึงไม่เพียงเหมาะสำหรับใช้ในโรงพยาบาลและหน่วยงานสาธารณสุข แต่ยังเหมาะสำหรับครัวเรือนที่ต้องการดูแลสุขภาพของสมาชิกทุกคนอย่างรอบด้าน

CHEMGENE HLD4H เป็นน้ำยาฆ่าเชื้อที่ได้รับการรับรองและทดสอบจากหลากหลายสถาบันทั้งในและต่างประเทศ เช่น:
Medimark Scientific
BluTest Laboratories
Chemila, SGS
กรมวิทยาศาสตร์การแพทย์
Intertek
มหาวิทยาลัยมหิดล (Mahidol University)
มี สารออกฤทธิ์ถึง 2 ชนิด ที่ฆ่าโควิด-19 ได้จริง
ฆ่าเชื้อไวรัส ภายใน 1 นาที ผ่านการทดสอบในห้องปฏิบัติการ
ป้องกันการติดเชื้อซ้ำบนพื้นผิวได้นานถึง 14 วัน
ใช้ได้กับเครื่องพ่นละอองฝอย ฉีดพ่นได้ทั่วพื้นที่
ระดับ High-Level Disinfectant เทียบเท่าน้ำยาในโรงพยาบาล

| หัวข้อ | CHEMGENE HLD4H | น้ำยาฆ่าเชื้อทั่วไป |
|---|---|---|
| ฆ่าเชื้อโควิด-19 | ฆ่าได้จริง ผ่านการทดสอบในห้องแล็บระดับสากล | ส่วนใหญ่ฆ่าโควิดไม่ตาย หรือไม่มีหลักฐานรองรับ |
| สารออกฤทธิ์ฆ่าเชื้อ | มี 2 ชนิด ที่ฆ่าโควิดได้จริง | มีแค่ 1 ชนิด หรือไม่มีสารฆ่าโควิดเลย |
| การรับรอง (ต่างประเทศ) | ได้รับรองจาก Medimark, BluTest, Intertek, SGS | ส่วนใหญ่มักไม่มี หรือไม่ผ่านมาตรฐาน |
| การรับรอง (ในประเทศ) | มหิดล, กรมวิทย์, โรงพยาบาล และองค์กรรัฐใช้งานจริง | มักไม่มีการรับรองในประเทศ |
| ความสามารถในการพ่น | ใช้กับเครื่องพ่นได้ดี ละอองกระจายทั่วถึง | บางชนิดไม่เหมาะกับการพ่น อาจก่อให้เกิดการระคายเคือง |
| ความคุ้มค่าในการใช้งาน | เจือจางได้ถึง 1:200 ประหยัด ใช้ได้นาน | เจือจางได้น้อย หรือใช้แบบเข้มข้น เปลืองและแพงระยะยาว |
| ระยะเวลาการปกป้องพื้นผิว | อยู่ได้นาน 14 วัน | ส่วนใหญ่อยู่ได้เพียง 1-2 วัน |
| ความน่าเชื่อถือ | ใช้จริงในภาคราชการ โรงเรียน โรงพยาบาล | ไม่พบข้อมูลการใช้งานจริง |

ไวรัสโควิด-19 (SARS-CoV-2), RSV, โรคมือ-เท้า-ปาก, ไข้หวัดใหญ่
ตามผลการทดสอบล่าสุดในปี 2023 พบว่าผลิตภัณฑ์ น้ำยาฆ่าเชื้อ CHEMGENE HLD4H มีความสามารถในการฆ่าเชื้อไวรัสและเชื้อโรคต่างๆ ได้รวมถึงไวรัสโควิด-19 (SARS-CoV-2), RSV, โรคมือ-เท้า-ปาก, และไข้หวัดใหญ่ การพัฒนาผลิตภัณฑ์ที่มีประสิทธิภาพนี้เป็นสิ่งที่มีความสำคัญในการป้องกันและควบคุมการระบาดของโรคในชุมชนและสถานที่ต่างๆ ซึ่งเป็นขั้นตอนที่สำคัญในการสร้างสุขภาพที่ดีให้กับประชาชนโดยรวม
อัพเดทผลการทดสอบล่าสุด
โรคไอกรน (Pertussis) คือโรคติดเชื้อทางเดินหายใจเฉียบพลันที่เกิดจากแบคทีเรีย Bordetella pertussis ซึ่งสามารถแพร่กระจายได้ง่ายผ่านละอองฝอยในอากาศเมื่อผู้ติดเชื้อไอหรือจาม เชื้อโรคนี้พบได้บ่อยในเด็กเล็ก แต่สามารถเกิดขึ้นได้ในคนทุกวัย หากไม่ได้รับวัคซีนป้องกัน
เพื่อใช้ในห้องปฏิบัติการทดสอบของตน โดยเป็นส่วนหนึ่งของการตอบสนองต่อการระบาดใหญ่ของ Covid-19
สารฆ่าเชื้อบนพื้นผิวห้องปฏิบัติการระดับสูงของ Chemgene น้ำยาฆ่าเชื้อ ที่ผสมผสานโมเลกุลของสารออกฤทธิ์ที่ได้รับการปรับปรุงเข้ากับเทคโนโลยีการทำความสะอาดไมเซลล์ เพื่อให้การเจาะผนังเซลล์อย่างรวดเร็วเพื่อให้แน่ใจว่าเซลล์จะตายอย่างรวดเร็ว การผสมผสานกันอย่างลงตัวของเทคโนโลยีและส่วนผสมออกฤทธิ์ช่วยให้ น้ำยาฆ่าเชื้อโรค Chemgene สามารถทำงานได้เร็วกว่าสารฆ่าเชื้อส่วนใหญ่ และช่วยให้มั่นใจได้ว่ากระบวนการอะพอพโทซิส (การตายของเซลล์) จะเกิดขึ้นได้ แทนที่จะเพียงแต่ระงับกิจกรรมชั่วคราว
การทดสอบในห้องปฏิบัติการอิสระแสดงให้เห็นว่าไม่มีการกัดกร่อนหรือการเสื่อมสภาพ แม้ว่าจะแช่ในน้ำซ้ำๆ เป็นเวลานานเมื่อใช้กับเหล็กสเตนเลส เหล็กเหนียว อะลูมิเนียม ทองแดง ทองเหลือง ชิ้นส่วนยาง พลาสติก ไฟเบอร์กลาส พื้นสังเคราะห์ เครื่องมือและอุปกรณ์ต่างๆ
เคมจีนมีจำหน่ายสองสูตร - ยูคาลิปตัสใสและยูคาลิปตัสสีฟ้า มีประสิทธิภาพในการต่อต้านเชื้อ Mycobacteria เชื้อรา แบคทีเรีย และไวรัส (รวมถึง Covid-19 หรือ SARS-CoV-2 ได้ใน 1 นาที)
Dr. Martin Moncrieffe จากภาควิชาชีวเคมี มหาวิทยาลัยเคมบริดจ์ รับรองว่า ” สูตร HLD4…....มีประสิทธิภาพมากในการตกตะกอน/ทำให้ DNA และ RNA เสื่อมสภาพ”

CHEMGENE น้ำยาฆ่าเชื้อ ที่สามารถเจือจางได้ 200 เท่าหรือ 1,000 ลิตรต่อน้ำยาต้นฉบับ อย่างไรก็ตาม การเจือจางจำเป็นต้องทำตามคำแนะนำในฉลากผลิตภัณฑ์เพื่อให้ได้ผลลัพธ์ที่เหมาะสมและมีประสิทธิภาพในการฆ่าเชื้อโรคในสภาพแวดล้อมต่าง ๆ โปรดทราบว่าการเจือจางน้ำยาฆ่าเชื้ออาจมีผลกระทบต่อประสิทธิภาพของสารฆ่าเชื้อและความปลอดภัยในการใช้งานด้วย ดังนั้นควรทำการเจือจางตามข้อแนะนำของผู้ผลิตเพื่อประสิทธิภาพและความปลอดภัยในการใช้งานที่เหมาะสมที่สุด

เพื่อตรวจสอบประสิทธิภาพในการติดเชื้อของ "CHEMGENE HLD4H" ต่อโรคทางเดินหายใจเฉียบพลันรุนแรงโคโรนาไวรัส 2 (SARS-CoV-2) ที่มีความเข้มข้น 1:100 โดยมีเวลาสัมผัส 1 นาที ผลิตภัณฑ์ที่ทดสอบมีประสิทธิภาพตามที่แสดงในตาราง
เพื่อตรวจสอบประสิทธิภาพในการกำจัดไวรัสของ "CHEMGENE HLD4H" ต่อเชื้อไวรัสโคโรนา 229E ในมนุษย์ (ATCC® VR-740™) ให้เช็ดผลิตภัณฑ์ที่ทดสอบซึ่งมีความเข้มข้น 1:50 ลงบนพื้นผิวกระจกที่ทำความสะอาดแล้วปล่อยทิ้งไว้ที่อุณหภูมิห้องเป็นเวลา 7 และ 14 วัน . ที่เวลาสัมผัส 1 นาที ผลิตภัณฑ์ที่ทดสอบมีประสิทธิภาพดังแสดงในตาราง

มีการตรวจวิเคราะห์ประสิทธิภาพของผลิตภัณฑ์ CHEMGENE HLD4H โดยใช้ความเข้มข้น 1:100 ทดสอบกับเชื้อไวรัส SARS-CoV-2 ซึ่งเป็นไวรัสที่ก่อให้เกิดโรคโควิด-19 ในคน

เพื่อประเมินประสิทธิภาพของผลิตภัณฑ์ CHEMGENE HLD4H ในการฆ่าเชื้อไวรัสที่เป็นอันตรายต่อสุขภาพของมนุษย์ ได้มีการดำเนินการ ทดสอบในห้องปฏิบัติการ ภายใต้เงื่อนไขที่ควบคุมอย่างเคร่งครัด
จากการตรวจวิเคราะห์ในห้องปฏิบัติการภายใต้เงื่อนไขควบคุม เพื่อประเมินความสามารถในการฆ่าเชื้อไวรัสของผลิตภัณฑ์ CHEMGENE HLD4H ได้มีการทดสอบที่ความเข้มข้น 1:30 และ 1:60 โดยใช้เวลาในการสัมผัสเชื้อเพียง 1 นาที
ผลที่ได้พบว่า ไม่ว่าจะเป็นที่ความเข้มข้น 1:30 หรือ 1:60 ผลิตภัณฑ์สามารถ ลดจำนวนไวรัสได้มากกว่า 99.99% ซึ่งแสดงถึงประสิทธิภาพในการฆ่าเชื้อไวรัสได้ในระดับสูง (High-Level Disinfection)
การลดจำนวนไวรัสที่มากกว่า 4 log10 เป็นค่าที่ผ่านเกณฑ์มาตรฐานระดับสากลสำหรับผลิตภัณฑ์ฆ่าเชื้อ ซึ่งหมายความว่า CHEMGENE HLD4H สามารถกำจัดไวรัสได้อย่างรวดเร็วและมีประสิทธิภาพ
หมายเหตุ: การลดเชื้อในระดับ ≥ 4 log10 เป็นค่ามาตรฐานสำหรับการยืนยันว่าผลิตภัณฑ์มีคุณสมบัติฆ่าเชื้อระดับสูง (High-Level Disinfection)


ฆ่าเชื้อ Covid-19 ภายใน 1 นาที 99.85%
CHEMGENE HLD4H เป็นผลิตภัณฑ์ที่สามารถฆ่าเชื้อโรคทุกชนิด และเป็น น้ำยาฆ่าเชื้อโควิด ที่สามารถฆ่าเชื้อ Covid-19 ภายในเวลา 1 นาทีด้วยประสิทธิภาพที่มีอยู่ที่ 99.85%
Chemgene มีส่วนผสมออกฤทธิ์ที่ผ่านการรับรอง 2 ชนิดซึ่ง
Chemgene น้ำยาฆ่าเชื้อโรค เป็นที่สุดแห่งการปกป้องที่เราคู่ควร! มีส่วนผสมออกฤทธิ์ที่ผ่านการรับรองไม่น้อยกว่า 2 ชนิด ที่มีความสามารถในการกำจัดเชื้อ Covid-19 ได้อย่างมั่นใจ เราสามารถพิสูจน์ความรักและความเอาใจใส่ของเราต่อครอบครัวและคนที่เรารักได้อย่างแท้จริงด้วย Chemgene คือเพื่อนที่ทำให้เรามั่นใจในการเผชิญหน้ากับเชื้อโรคได้อย่างมั่นคงและมั่นใจได้ว่าเราจะเอาชนะมันได้!


ผลิตภัณฑ์น้ำยาฆ่าเชื้อ CHEMGENE HLD4H ได้รับการพิสูจน์ทางวิทยาศาสตร์ว่ามีประสิทธิภาพในการฆ่าเชื้อไวรัสและแบคทีเรียในระดับสูง พร้อมทั้งได้รับการรับรองและทดสอบโดยหน่วยงานที่น่าเชื่อถือ ดังนี้:
ด้วยผลการทดสอบที่โปร่งใส และการรับรองจากหลายหน่วยงานทั้งในประเทศและต่างประเทศ CHEMGENE HLD4H จึงเป็นหนึ่งในผลิตภัณฑ์ฆ่าเชื้อที่คุณสามารถมั่นใจได้ในประสิทธิภาพและความปลอดภัย เหมาะสำหรับการใช้งานในบ้าน โรงเรียน โรงพยาบาล สำนักงาน และสถานที่สาธารณะ

น้ำยาฆ่าเชื้อสำหรับเครื่องมือแพทย์ระดับ Medical Grade
Medical Disinfectant for Instruments & Equipment
CHEMGENE HLD4H คือผลิตภัณฑ์น้ำยาฆ่าเชื้อประสิทธิภาพสูงที่ออกแบบมาเฉพาะสำหรับการทำความสะอาดและฆ่าเชื้อ เครื่องมือแพทย์ รวมถึงอุปกรณ์ที่ใช้ในห้องปฏิบัติการ ห้องผ่าตัด และสถานพยาบาลทั่วไป โดยสามารถทำลายเชื้อแบคทีเรีย เชื้อไวรัส และเชื้อราได้อย่างครอบคลุม
สูตรผสมเฉพาะที่รวมสารออกฤทธิ์หลายชนิด เพื่อให้ได้ผลลัพธ์ในการฆ่าเชื้อที่แม่นยำและครอบคลุมในทุกระดับของจุลชีพ
มาตรฐานการรับรอง (Certifications)ผลิตภัณฑ์ฆ่าเชื้อ CHEMGENE HLD4H ผ่านการรับรองคุณภาพระดับสากล:

การฆ่าเชื้อ เป็นกระบวนการสำคัญในการปกป้องคุณและคนรอบตัวจากการติดเชื้อไวรัสอย่างปลอดภัยและมีประสิทธิภาพ โดยเฉพาะในยุคที่ไวรัสสายพันธุ์ต่าง ๆ เช่น RSV และ COVID-19 ยังคงเป็นภัยคุกคามต่อสุขภาพ
ไวรัสอย่าง RSV (Respiratory Syncytial Virus) และ SARS-CoV-2 (ไวรัสโควิด-19) จัดอยู่ในกลุ่ม Envelope Virus หรือ ไวรัสที่มีชั้นไขมันห่อหุ้ม ซึ่งชั้นไขมันนี้เป็นส่วนสำคัญที่ไวรัสใช้ในการเกาะติดและเข้าสู่เซลล์ของร่างกายมนุษย์
ไวรัสห่อหุ้มประกอบด้วยองค์ประกอบสำคัญ ได้แก่:

สารฆ่าเชื้อ เช่น CHEMGENE HLD4H ออกฤทธิ์โดย ทำลายชั้นไขมันห่อหุ้มของไวรัส ส่งผลให้ไวรัสแตกตัวเป็นชิ้นเล็ก ๆ ไม่สามารถเกาะติดเซลล์หรือเพิ่มจำนวนในร่างกายได้อีกต่อไป
เมื่อชั้นไขมันถูกทำลาย:
CHEMGENE HLD4H ได้รับการออกแบบให้มีฤทธิ์ในการฆ่าเชื้อระดับสูง (High-Level Disinfectant) และผ่านการทดสอบตามมาตรฐาน EN14476 ซึ่งเป็นมาตรฐานสากลของยุโรปสำหรับการทดสอบประสิทธิภาพของสารฆ่าเชื้อไวรัส
CHEMGENE HLD4H จึงเหมาะอย่างยิ่งสำหรับใช้ในสถานพยาบาล พื้นที่สาธารณะ และสถานที่ที่ต้องการความสะอาดปลอดเชื้อระดับสูง

ได้รับการทดสอบอย่างมีประสิทธิภาพกับไวรัสที่มีชั้นไขมันห่อหุ้ม (Envelope Virus)
รวมถึงไวรัส Coronavirus SARS-CoV-2 ซึ่งเป็นสาเหตุของโรคโควิด-19
สามารถฆ่าเชื้อได้ภายในเวลาเพียง 1 นาที
ภายใต้การทดสอบตามมาตรฐานยุโรป EN14476 โดยสถาบันทดสอบชั้นนำ

ใช้งานควบคู่กับเครื่องพ่นฆ่าเชื้อ AIROFOG U260
เพื่อการกระจายละอองฝอยอย่างทั่วถึงในพื้นที่ เช่น ห้องผู้ป่วย ห้องเรียน สำนักงาน หรือพื้นที่ส่วนรวม
เครื่องพ่น AIROFOG : U260 จากเยอรมนี ออกแบบมาสำหรับการใช้งานกับน้ำยาฆ่าเชื้อโดยเฉพาะ
เพื่อผลลัพธ์ที่ดีที่สุด แนะนำให้ใช้ CHEMGENE HLD4H ร่วมกับเครื่องพ่น AIROFOG U260
เพื่อความปลอดภัยสูงสุดในทุกพื้นที่ของคุณ

ฆ่าเชื้อไวรัส พร้อมปกป้องพื้นผิวได้นานสูงสุด 14 วัน น้ำยาฆ่าเชื้อระดับ Medical Grade ผ่านการรับรองจากทั้งในและต่างประเทศ
ฆ่าเชื้อได้รวดเร็วภายใน 1 นาที คงประสิทธิภาพบนพื้นผิวได้นานถึง 14 วัน ต่อการปนเปื้อนใหม่ ช่วยลดความเสี่ยงจากเชื้อโรคที่สะสมบนพื้นผิวในชีวิตประจำวัน
CHEMGENE HLD4H — ทางเลือกใหม่ของการฆ่าเชื้อ ที่ไม่ใช่แค่สะอาด แต่ยังปกป้องได้ยาวนาน
หากต้องการใช้คำนี้ใน ภาพโปรโมต เช่น คำว่า
“ปกป้องเชื้อได้ยาวนานสูงสุด 14 วัน | 14 DAY SURFACE PROTECTION”

ป้องกันการแพร่ระบาดสู่ห้องเรียน ด้วยผลิตภัณฑ์ฆ่าเชื้อระดับการแพทย์
เพื่อความปลอดภัยของนักเรียน ครู และบุคลากรในโรงเรียน
แนะนำการใช้ ผลิตภัณฑ์ น้ำยาฆ่าเชื้อ CHEMGENE HLD4H



